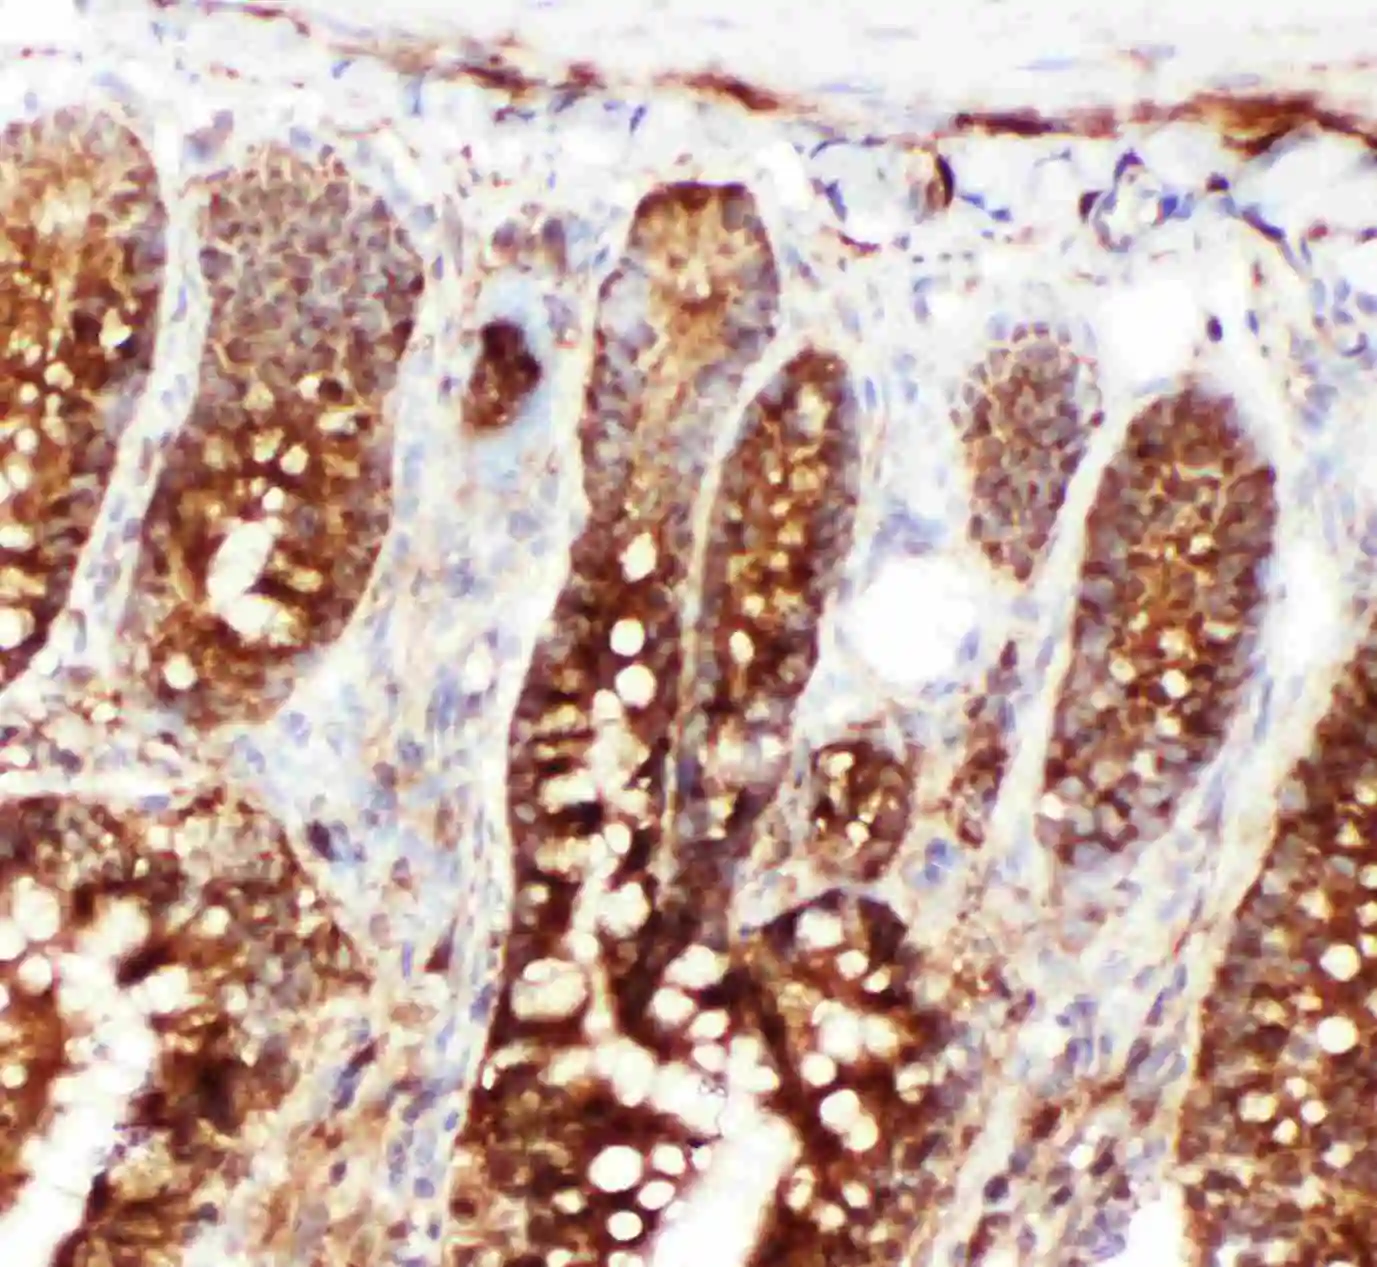

ICC/IF analysis of HeLa cell using GTX11573 Hsp70 antibody. Antigen retireval : Heat mediated antigen retrieval was performed in citrate buffer (pH6, epitope retrieval solution) for 20 mins Dilution : 1microg/ml
Hsp70 antibody
GTX11573
ApplicationsImmunoFluorescence, Western Blot, ImmunoCytoChemistry, ImmunoHistoChemistry, ImmunoHistoChemistry Frozen, ImmunoHistoChemistry Paraffin
Product group Antibodies
TargetHSPA1A
Overview
- SupplierGeneTex
- Product NameHsp70 antibody
- Delivery Days Customer9
- Application Supplier NoteWB: 0.1-0.5microg/ml. ICC/IF: 0.5-1microg/ml. IHC-P: 0.5-1microg/ml. IHC-Fr: 0.5-1microg/ml. *Optimal dilutions/concentrations should be determined by the researcher.Not tested in other applications.
- ApplicationsImmunoFluorescence, Western Blot, ImmunoCytoChemistry, ImmunoHistoChemistry, ImmunoHistoChemistry Frozen, ImmunoHistoChemistry Paraffin
- CertificationResearch Use Only
- ClonalityPolyclonal
- Concentration500 ug/ml
- ConjugateUnconjugated
- Gene ID3303
- Target nameHSPA1A
- Target descriptionheat shock protein family A (Hsp70) member 1A
- Target synonymsHEL-S-103, HSP70, HSP70-1, HSP70-1A, HSP70-2, HSP70.1, HSP70.2, HSP70I, HSP72, HSPA1, heat shock 70 kDa protein 1A, HSP70-1/HSP70-2, HSP70.1/HSP70.2, Heat shock 70 kDa protein 1B, Heat shock 70 kDa protein 2, dnaK-type molecular chaperone HSP70-1, epididymis secretory protein Li 103, epididymis secretory sperm binding protein, heat shock 70 kDa protein 1, heat shock 70 kDa protein 1/2, heat shock 70 kDa protein 1A/1B, heat shock 70kD protein 1A, heat shock 70kDa protein 1A, heat shock protein family A member 1A, heat shock-induced protein
- HostRabbit
- IsotypeIgG
- Protein IDP0DMV8
- Protein NameHeat shock 70 kDa protein 1A
- Storage Instruction-20°C or -80°C,2°C to 8°C
- UNSPSC12352203

![IHC-P analysis of human prostate carcinoma tissue using GTX22787 Hsp70 antibody [5A5]. Left : Primary antibody Right : Negative control without primary antibody Antigen retrieval : heat induced antigen retrieval was performed using 10mM sodium citrate (pH6.0) buffer, microwaved for 8-15 minutes Dilution : 1:100](https://www.genetex.com/upload/website/prouct_img/normal/GTX22787/GTX22787_1110_IHC-P_w_23060620_738.webp)
![IHC-P analysis of human breast carcinoma tissue using GTX25439 Hsp70 antibody [3A3]. Left : Primary antibody Right : Negative control without primary antibody Antigen retrieval : heat induced antigen retrieval was performed using 10mM sodium citrate (pH6.0) buffer, microwaved for 8-15 minutes Dilution : 1:50](https://www.genetex.com/upload/website/prouct_img/normal/GTX25439/GTX25439_1283_IHC-P_w_23060722_400.webp)
![IHC-P analysis of human prostate carcinoma tissue using GTX25442 Hsp70 antibody [2A4]. Left : Primary antibody Right : Negative control without primary antibody Antigen retrieval : heat induced antigen retrieval was performed using 10mM sodium citrate (pH6.0) buffer, microwaved for 8-15 minutes Dilution : 1:200](https://www.genetex.com/upload/website/prouct_img/normal/GTX25442/GTX25442_1286_IHC-P_w_23060722_618.webp)
![IHC-P analysis of human prostate carcinoma tissue using GTX25444 Hsp70 antibody [4G4]. Left : Primary antibody Right : Negative control without primary antibody Antigen retrieval : heat induced antigen retrieval was performed using 10mM sodium citrate (pH6.0) buffer, microwaved for 8-15 minutes Dilution : 1:20](https://www.genetex.com/upload/website/prouct_img/normal/GTX25444/GTX25444_1289_IHC-P_w_23060722_635.webp)
